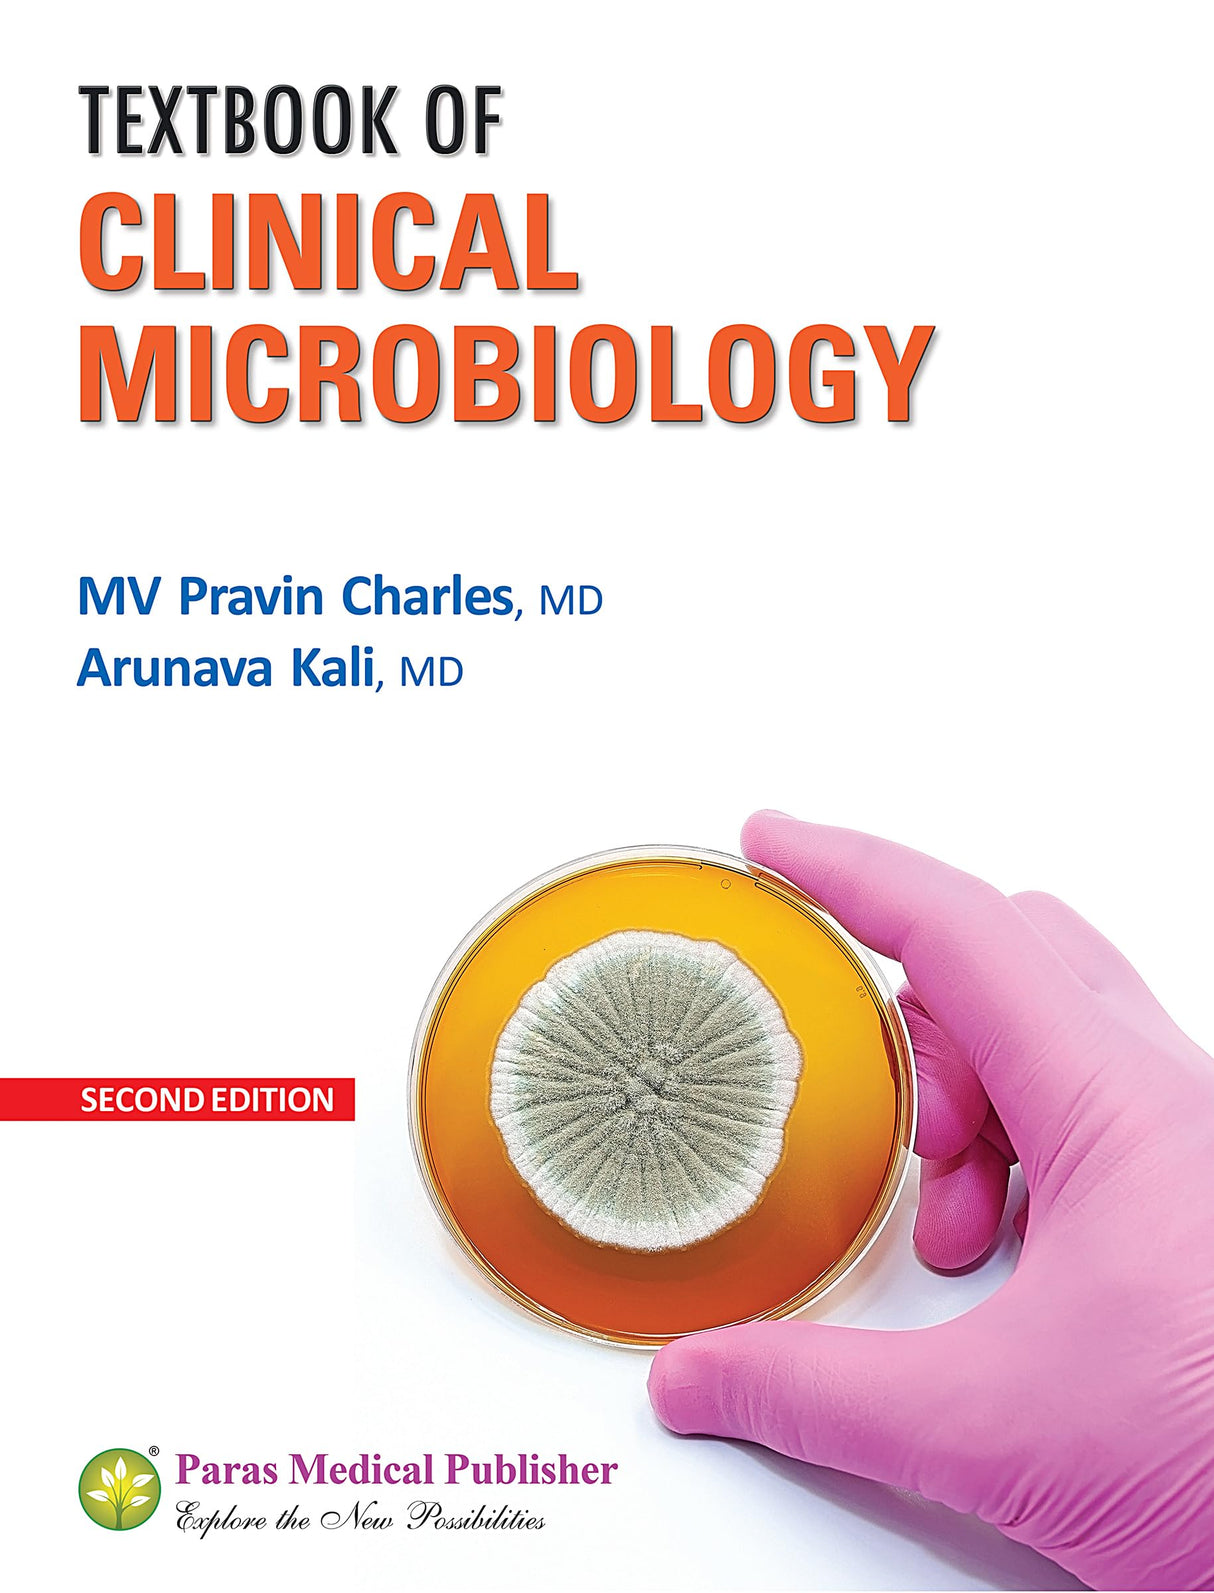
Textbook of Clinical Microbiology (2nd Edition)

Textbook of Clinical Microbiology (2nd Edition)
Textbook of Clinical Microbiology (2nd Edition) is backordered and will ship as soon as it is back in stock.
Couldn't load pickup availability
Genuine Products Guarantee
Genuine Products Guarantee
We guarantee 100% genuine products, and if proven otherwise, we will compensate you with 10 times the product's cost.
Delivery and Shipping
Delivery and Shipping
Products are generally ready for dispatch within 1 day and typically reach you in 3 to 5 days.
Book Details
-
Publisher: Paras Medical Publisher
-
Language: English
-
Edition: Standard Edition (2025)
-
Pages: 835
-
Cover: Paperback
-
ISBN: 9788181915887
-
Weight: 2 kg
About the Book
Published by Paras Medical Publisher, this Standard Edition (2025) is a comprehensive and authoritative academic resource designed for medical students and professionals. With 835 pages of detailed, well-structured, and up-to-date content, the book ensures clarity, reliability, and strong conceptual understanding. Its English-language presentation offers easy readability, while the latest edition reflects refined explanations and contemporary updates. The durable paperback format paired with its in-depth coverage makes it an essential reference for coursework, exam preparation, and clinical learning.